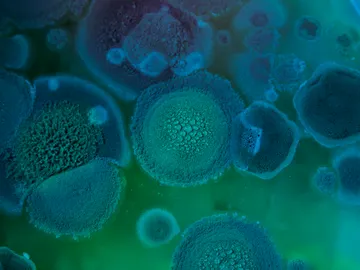
Hongo Aspergillus fumigatus Hongo Aspergillus fumigatus

Astronomía, divulgación, descubrimientos, ecología, innovación...

Qué es la poliomielitis, la enfermedad que marcó la vida de Robert Redford

Consejos para evitar la infección más común de los amantes de la piscinas

¿Qué es una infección polimicrobiana? La enfermedad que padece el Papa Francisco